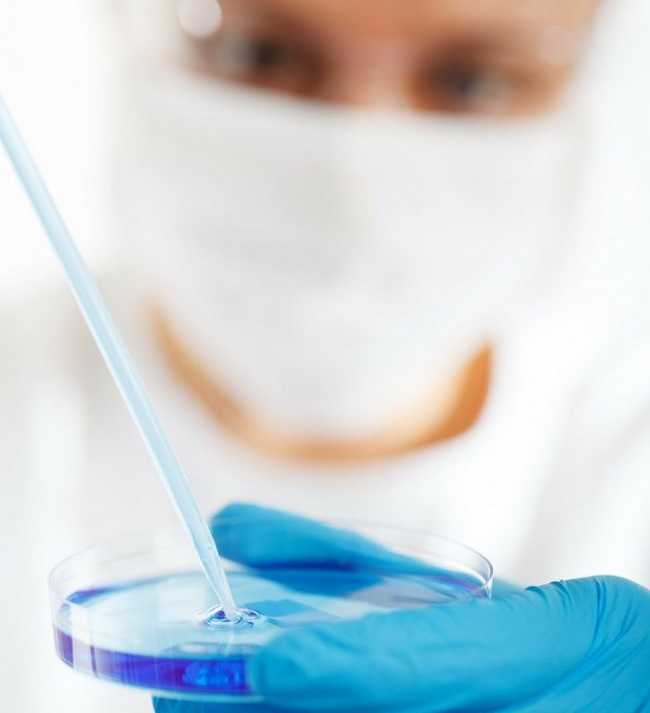
laboratorio test bilogia

PIEMONTE -08-06-2021 - Oltre alla funzione di controllo ambientale, l’Arpa Piemonte potrà svolgere anche attività di ricerca sull’ambiente. Lo prevede la legge di riordino in esame in prima Commissione, presieduta da Carlo Riva Vercellotti.
Illustrando nel pomeriggio le modifiche alla legislazione regionale previste nel provvedimento, l’assessore all’ambiente Matteo Marnati ha citato anche gli articoli che introducono, oltre le attività di controllo, anche quelle di ricerca: “l'Arpa realizza attività di ricerca e sperimentazione scientifica e tecnica, in autonomia o anche in collaborazione con l'Istituto superiore per la protezione e la ricerca ambientale, con le altre agenzie regionali e delle province autonome e con altri soggetti operanti nel campo della ricerca. Arpa adegua il proprio ordinamento interno per svolgere le attività di ricerca”.
Siamo ancora alla fasi d’illustrazione del provvedimento, che dovrà poi essere varato in Commissione e approvato dall’aula, ma le intenzioni della maggioranza di far crescere la ricerca all’interno dell’Arpa sono esplicite.
Anche gli assessori Andrea Tronzano e Marco Gabusi hanno illustrato le modifiche legislative proposte per i loro settori di intervento: il personale per Gabusi, l’attività estrattiva per Tronzano. Su questo ultimo tema perplessità sulle proposte sono state espresse dai consiglieri di minoranza Domenico Rossi (Pd), Sean Sacco (M5s) e Giorgio Bertola (m4o), che hanno annunciato emendamenti.
La Commissione ha anche dato il via libera alla Pdl che introduce modifiche alla legge sul difensore civico, illustrata dal presidente del Consiglio Stefano Allasia. Le novità intendono colmare il vuoto normativo che si verifica in occasione di dimissioni anticipate del difensore civico, in modo da garantire la continuità operativa dell’ufficio.
La Commissione ha infine esaminato il programma annuale di ricerca dell’Ires Piemonte, illustrato dall’assessore Fabrizio Ricca. Marco Grimaldi (Luv) ha ricordato i temi di ricerca proposti dal Comitato per la normazione e inseriti nel programma: il lavoro povero in Piemonte, la riconversione ecologica, l’edilizia sociale, la telemedicina, le ricadute socioeconomiche dell’emergenza Covid. (C.S)